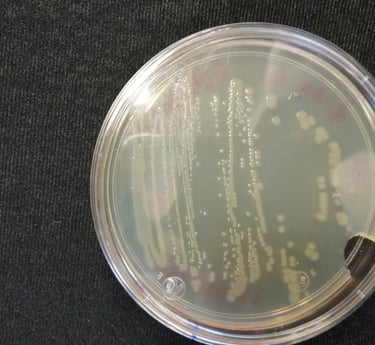

Hongos
Los hongos fitopatógenos son el grupo de agentes causales más diverso y económicamente dominante, definidos por su estructura eucariota y crecimiento filamentoso (micelio). Su infección inicia mediante esporas, penetrando el tejido vegetal a través de estructuras especializadas o secreción enzimática. La patogénesis causa una amplia gama de daños, desde pudriciones y tizones foliares hasta la obstrucción vascular (marchitez), afectando gravemente la productividad. Géneros clave como Fusarium, Puccinia (royas) y Botrytis son focos de estudio constante. La gestión eficiente se basa en el desarrollo de fungicidas selectivos y la resistencia genética.